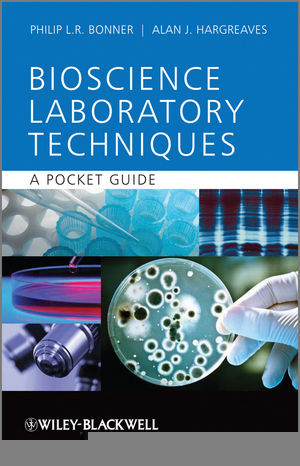
Basic Bioscience Laboratory Techniques - Philip L.R. Bonner, Alan J. Hargreaves

Basic Bioscience Laboratory Techniques
John Wiley & Sons Inc (Verlag)
978-0-470-74309-6 (ISBN)
- Titel erscheint in neuer Auflage
- Artikel merken
In short, this is a 'must-have' for all first year bioscience students struggling to get to grips with this vitally important element of their course.
Dr Philip L.R. Bonner and Dr Alan J. Hargreaves, both of the School of Science and Technology, Nottingham Trent University.
Preface ix
Glossary xi
Abbreviations xvii
1 The preparation of solutions in bioscience research 1
1.1 Introduction 1
1.2 Concentration 2
1.3 Using balances to weigh out reagents 3
1.4 Practical considerations when making a 1.0 M solution 6
1.5 Dilutions and the use of pipettes 11
1.6 Water, acids and bases 15
1.7 Buffers 21
1.8 The equilibrium/dissociation constant (Ka) for an acid or base and the Henderson–Hasselbalch equation 24
1.9 Summary 26
2 Microscopy 27
2.1 Introduction 27
2.2 Microscopes – general principles 29
2.3 Principles of image formation 30
2.4 Light microscopy 32
2.5 Electron microscopy 46
2.6 Summary 49
3 Spectrophotometry 51
3.1 Introduction 51
3.2 The electromagnetic spectrum 51
3.3 The absorbance of light 54
3.4 Absorbtion spectrophotometry 56
3.5 The laws of the absorbance of light 57
3.6 The Beer Lambert law 61
3.7 Spectrophotometers 63
3.8 Applications of spectrophotometry in bioscience 68
3.9 Summary 73
4 Data analysis and presentation 74
4.1 Introduction 74
4.2 Statistical analysis of data: some key definitions 76
4.3 Distributions 79
4.4 Statistical comparison of data 85
4.5 Presentation, structure and organization of data in laboratory reports 94
4.6 Summary 100
5 The extraction and clarification of biological material 103
5.1 General introduction 103
5.2 Extraction 103
5.3 Extraction methods for animal and plant tissue 105
5.4 Extraction methods for bacteria 107
5.5 Clarification 108
5.6 Centrifugation techniques 115
5.7 Points of good practice in centrifugation 119
5.8 Summary 120
6 Electrophoresis of proteins and nucleic acids 121
6.1 General introduction 121
6.2 Separation of protein mixtures by gel electrophoresis 122
6.3 Other electrophoretic techniques applied to proteins 136
6.4 Separation of nucleic acids by gel electrophoresis 137
6.5 Applications of gel electrophoresis of nucleic acids 141
6.6 Summary 146
7 Chromatography 147
7.1 General introduction 147
7.2 The theory of chromatography 147
7.3 Factors to consider in chromatography 152
7.4 Methods used to elute samples in chromatography 153
7.5 Different types of chromatography and what properties can be used to separate molecules 153
7.6 Thin layer chromatography (TLC) 156
7.7 High pressure liquid chromatography (HPLC) 158
7.8 Gas liquid chromatography (GLC) 161
7.9 Ion exchange chromatography (IEX) 162
7.10 Size exclusion chromatography 164
7.11 Affinity chromatography 166
7.12 Summary 167
8 Cell culture techniques 169
8.1 Introduction 169
8.2 Growth and maintenance of cells in culture 174
8.3 Summary 192
Suggestions for further reading 195
Index 198
| Erscheint lt. Verlag | 14.3.2011 |
|---|---|
| Verlagsort | New York |
| Sprache | englisch |
| Maße | 120 x 179 mm |
| Gewicht | 198 g |
| Themenwelt | Naturwissenschaften ► Biologie ► Mikrobiologie / Immunologie |
| ISBN-10 | 0-470-74309-3 / 0470743093 |
| ISBN-13 | 978-0-470-74309-6 / 9780470743096 |
| Zustand | Neuware |
| Informationen gemäß Produktsicherheitsverordnung (GPSR) | |
| Haben Sie eine Frage zum Produkt? |
aus dem Bereich



